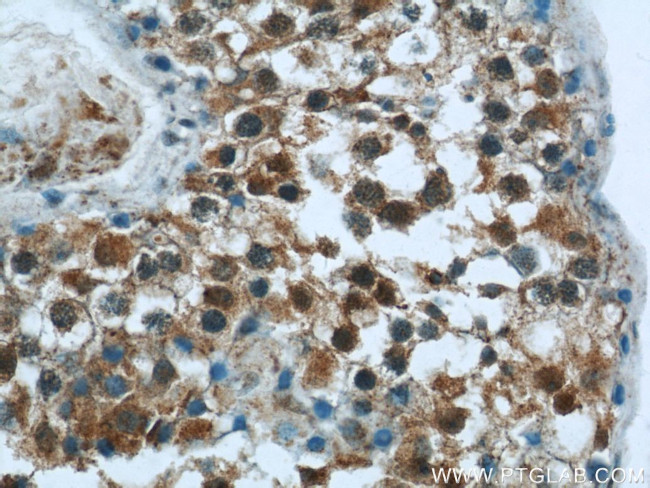
DNAH14 Antibody in Immunohistochemistry (Paraffin) (IHC (P))

Search
Proteintech
DNAH14 Polyclonal Antibody
{{$productOrderCtrl.translations['antibody.pdp.commerceCard.promotion.promotions']}}
{{$productOrderCtrl.translations['antibody.pdp.commerceCard.promotion.viewpromo']}}
{{$productOrderCtrl.translations['antibody.pdp.commerceCard.promotion.promocode']}}: {{promo.promoCode}} {{promo.promoTitle}} {{promo.promoDescription}}. {{$productOrderCtrl.translations['antibody.pdp.commerceCard.promotion.learnmore']}}
产品信息
25072-1-AP
种属反应
宿主/亚型
分类
类型
抗原
偶联物
形式
浓度
规格
纯化类型
保存液
内含物
保存条件
运输条件
产品详细信息
Immunogen sequence: METFIPIDL TTENQEMDKE ETKTKPRLLR YEEKKYEDVK PLETQPAEIA EKETLEYKTV RTFSESLKSE KTEDYLRESI IQQHMVSPEP ASLKEKGKSR RKKDQTHACP NVRKARPVSY DRTEPKDDDV IRNIIRLREK LGWQTILPQH SLKYGSSKIA IQKITLKKPL EDDGEFVYCL PRKSPKSLYN PYDLQVVSAH TAKHCKEFWV ITASFISKVI NIVGSVKEVE LIPTLEWLSE RRHYYLLRQF KIFSDFRMNK AFVTWKLNVK RIKTEKSRSF LYHHLFLADD LFQTCLVYIR GLCEDAINLK NYNDHENNLS AICLVKLDSS RTYSLDEFCE EQLQQATQAL K (1-350 aa encoded by BC119716)
靶标信息
Force generating protein of respiratory cilia. Produces force towards the minus ends of microtubules. Dynein has ATPase activity; the force-producing power stroke is thought to occur on release of ADP. Involved in sperm motility; implicated in sperm flagellar assembly.
仅用于科研。不用于诊断过程。未经明确授权不得转售。
篇参考文献 (0)
生物信息学
蛋白别名: Axonemal beta dynein heavy chain 14; Ciliary dynein heavy chain 14; Dynein axonemal heavy chain 14; dynein heavy chain 14, axonemal; dynein, axonemal, heavy polypeptide 14
基因别名: C1orf67; DNAH14; Dnahc14; HL-18; HL18
UniProt ID: (Human) Q0VDD8
Entrez Gene ID: (Human) 127602